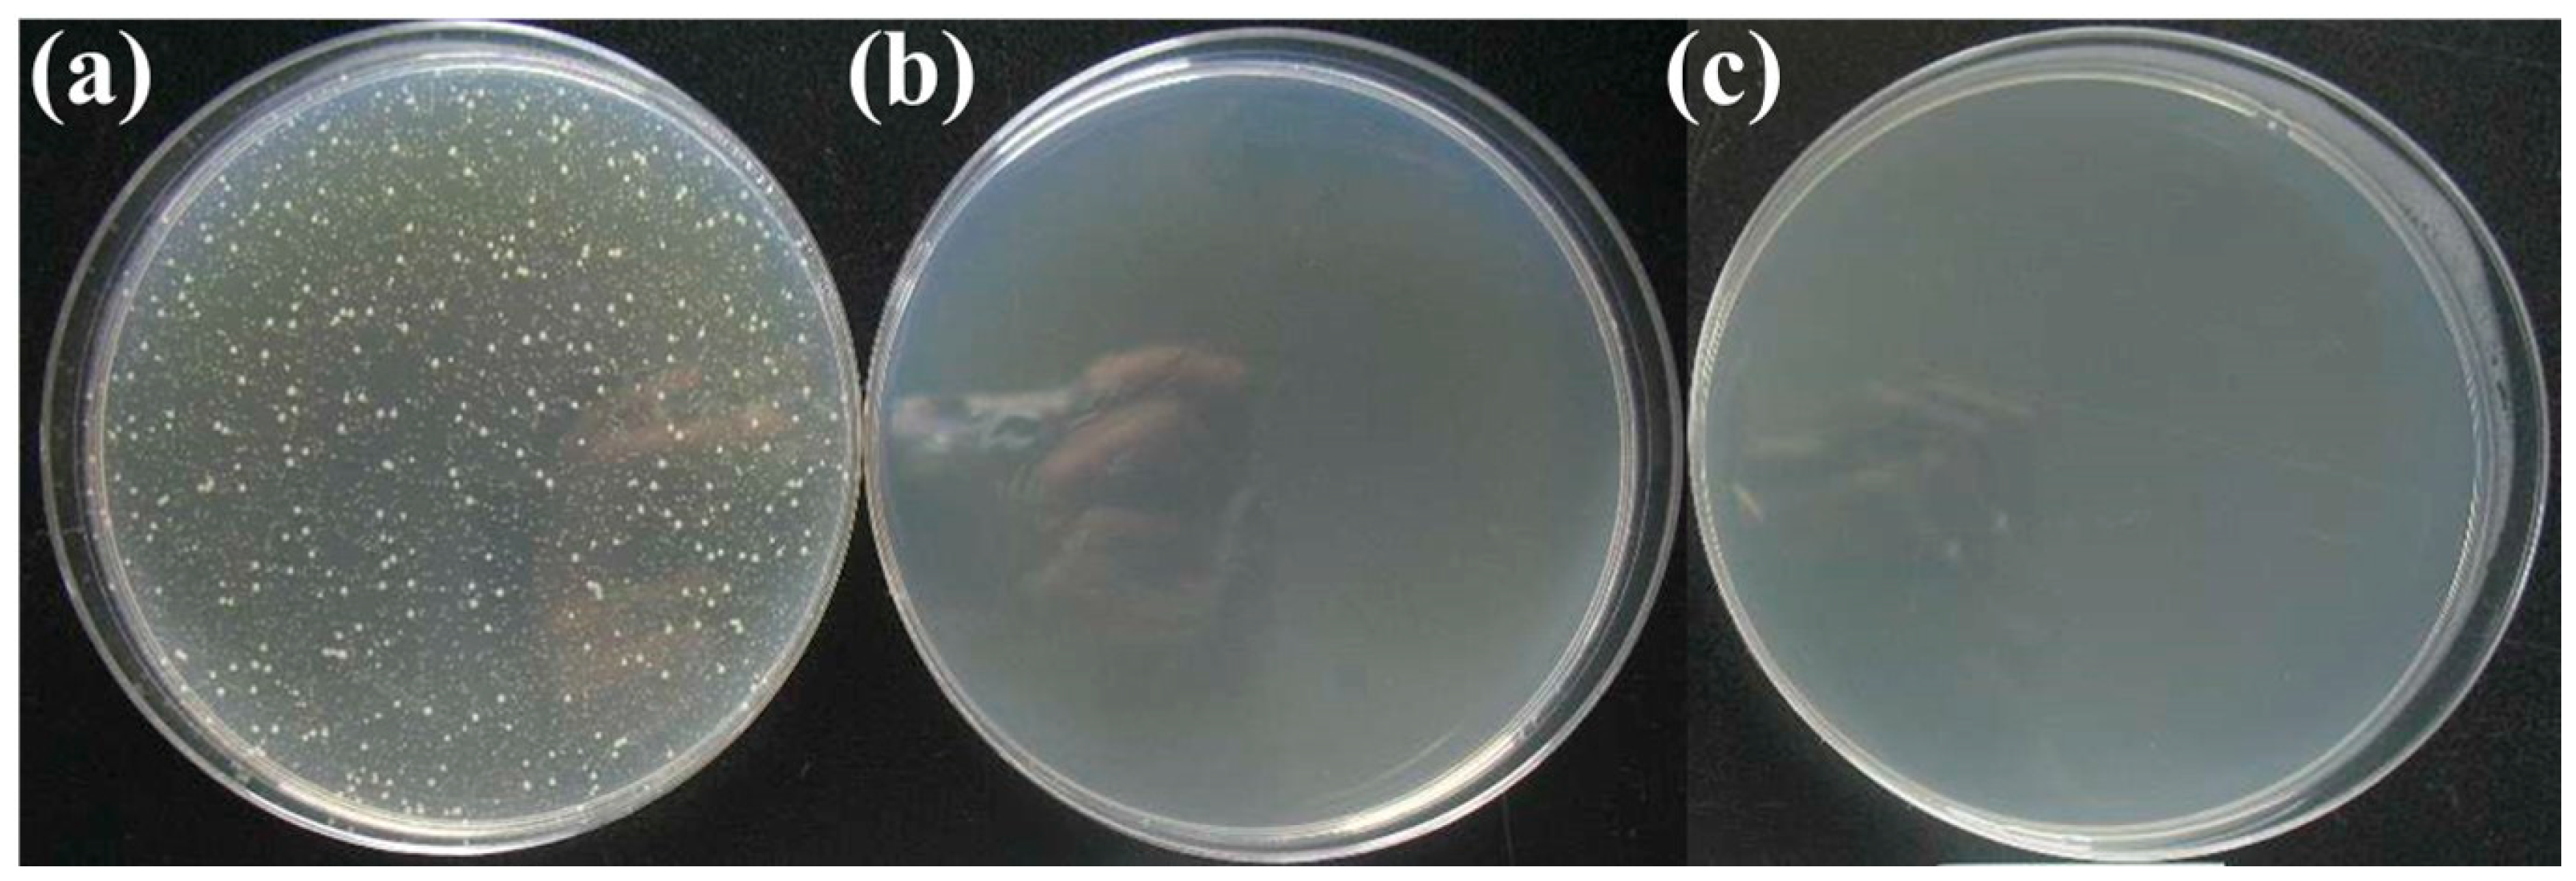
Materials 13 00403 g003 Materials 13 00403 g003

A Novel Design to Enhance the Mechanical Properties in Cu-Bearing Antibacterial Stainless Steel
Abstract
1. Introduction
2. Materials and Experiments
3. Results and Discussion
3.1. Microstructure
3.2. Antibacterial Test
3.3. Hardness
3.4. Formability
3.5. Solid Solubility of Copper
3.6. Segregation
3.7. Nucleating Location
4. Conclusions
- The microstructure observation shows that nano-sized copper precipitation can be formed during low temperature aging following the antibacterial annealing. Bimodal precipitations are obtained, namely the rod-shaped copper precipitation and nano-sized copper precipitation.
- Due to the low segregation coefficient of copper, the nano-sized copper precipitations nucleate and grow uniformly in the material. With the increase of aging temperature and aging time, the size of the nano-sized copper precipitation increases. The optimal aging process is aging at 550 °C for one hour.
- The mechanical properties can be also improved by decreasing the antibacterial annealing time. The best process combination is antibacterial annealing at 800 °C for half an hour followed by aging at 550 °C for one hour. Under this process, the yield strength and tensile strength of the material get the maximum increase. Plasticity and formability is only slightly reduced, and at the same time, the excellent antibacterial property remains.
Author Contributions
Funding
Conflicts of Interest
References
- Xi, T.; Yang, C.; Babar Shahzad, M.; Yang, K. Study of the Processing Map and Hot Deformation Behavior of a Cu-Bearing 317Ln Austenitic Stainless Steel. Mater. Des. 2015, 87, 303–312. [Google Scholar] [CrossRef]
- Xiang, H.; Guo, P. Effects of Antibacterial Aging Treatment on Microstructure and Properties of Copper-Containing Duplex Stainless Steel I. Microstructure and Evolution of Copper-Rich Phase. Acta Metall. Sin. 2012, 48, 1081–1088. [Google Scholar] [CrossRef]
- Xiang, H.; Gu, X. Effects of Antibacterial Aging Treatment on Microstructure and Properties of Copper-Containing Duplex Stainless Steel Ii. Corrosion Resistance and Antibacterial Properties. Acta Metall. Sin. 2012, 48, 1089–1096. [Google Scholar] [CrossRef]
- Zhang, Z.X.; Lin, G.; Xu, Z. Effects of Light Pre-Deformation on Pitting Corrosion Resistance of Copper-Bearing Ferrite Antibacterial Stainless Steel. J. Mater. Process. Technol. 2008, 205, 419–424. [Google Scholar] [CrossRef]
- Sun, S.; Zhao, A.; Zeng, Q.; Yin, H. Effect of Continuous Annealing Temperature on Microstructure and Properties of Ultra-Purified Ferritic Stainless Steel. Steel Res. Int. 2017, 88, 1600347. [Google Scholar] [CrossRef]
- Ren, L.; Nan, L.; Yang, K. Study of Copper Precipitation Behavior in a Cu-Bearing Austenitic Antibacterial Stainless Steel. Mater. Des. 2011, 32, 2374–2379. [Google Scholar] [CrossRef]
- Ren, L.; Yang, K.; Guo, L.; Chai, H. Preliminary Study of Anti-Infective Function of a Copper-Bearing Stainless Steel. Mater. Sci. Eng. C-Mater. 2012, 32, 1204–1209. [Google Scholar] [CrossRef]
- Shypylenko, A.; Pshyk, A.V.; Grzeskowiak, B.; Medjanik, K.; Peplinska, B.; Oyoshi, K.; Pogrebnjak, A.; Jurga, S.; Coy, E. Effect of Ion Implantation on the Physical and Mechanical Properties of Ti-Si-N Multifunctional Coatings for Biomedical Applications. Mater. Des. 2016, 110, 821–829. [Google Scholar] [CrossRef]
- Ren, L.; Xu, L.; Feng, J.; Zhang, Y.; Yang, K. In Vitro Study of Role of Trace Amount of Cu Release from Cu-Bearing Stainless Steel Targeting for Reduction of in-Stent Restenosis. J. Mater. Sci. Mater. Med. 2012, 23, 1235–1245. [Google Scholar] [CrossRef]
- Gomes, S.; Vichery, C.; Descamps, S.; Martinez, H.; Kaur, A.; Jacobs, A.; Nedelec, J.; Renaudin, G. Cu-Doping of Calcium Phosphate Bioceramics: From Mechanism to the Control of Cytotoxicity. Acta Biomater. 2018, 65, 462–474. [Google Scholar] [CrossRef]
- Shi, M.; Chen, Z.; Farnaghi, S.; Friis, T.; Mao, X.; Xiao, Y.; Wu, C. Copper-Doped Mesoporous Silica Nanospheres, a Promising Immunomodulatory Agent for Inducing Osteogenesis. Acta Biomater. 2016, 30, 334–344. [Google Scholar] [CrossRef] [PubMed]
- Sun, S.; Yin, F.; Liu, Y.; Zhang, W.; Zhao, A.; Han, Q. Deformation-Induced Dissolution of Copper Precipitation in 1.5Wt%Cu-Bearing Antibacterial Fe-17Wt%Cr Alloy during Plastic Deformation Process. Mater. Des. 2018, 157, 469–477. [Google Scholar] [CrossRef]
- Bahmani-Oskooee, M.; Hossein Nedjad, S.; Samadi, A.; Kozeschnik, E. Cu-Bearing, Martensitic Stainless Steels for Applications in Biological Environments. Mater. Des. 2017, 130, 442–451. [Google Scholar] [CrossRef]
- Wang, S.; Yang, C.; Shen, M.; Yang, K. Effect of Aging on Antibacterial Performance of Cu-Bearing Martensitic Stainless Steel. Mater. Technol. 2014, 29, 257–261. [Google Scholar] [CrossRef]
- Dlouhy, J.; Podany, P.; Dzugan, J. Strengthening From Cu Addition in 0.2C-(1-2)Mn Steels During Tempering. Materials 2019, 12, 247. [Google Scholar] [CrossRef]
- Shi, X.; Yan, W.; Wang, W.; Shan, Y.; Yang, K. Novel Cu-Bearing High-Strength Pipeline Steels with Excellent Resistance to Hydrogen-Induced Cracking. Mater. Des. 2016, 92, 300–305. [Google Scholar] [CrossRef]
- Holzer, I.; Kozeschnik, E. Computer Simulation of the Yield Strength Evolution in Cu-Precipitation Strengthened Ferritic Steel. Mater. Sci. Eng. A 2010, 527, 3546–3551. [Google Scholar] [CrossRef]
- Rana, R.; Bleck, W.; Singh, S.B.; Mohanty, O.N. Development of High Strength Interstitial Free Steel by Copper Precipitation Hardening. Mater. Lett. 2007, 61, 2919–2922. [Google Scholar] [CrossRef]
- Zhou, W.H.; Guo, H.; Xie, Z.J.; Shang, C.J.; Misra, R.D.K. Copper Precipitation and its Impact on Mechanical Properties in a Low Carbon Microalloyed Steel Processed by a Three-Step Heat Treatment. Mater. Des. 2014, 63, 42–49. [Google Scholar] [CrossRef]
- Guo, H.; Cheng, J.; Yang, S.; He, X. Influence of Combined Cu and Nb Addition on the Quenched Microstructure and Precipitation during Tempering in Ultra-Low Carbon Steels. J. Alloys Compd. 2013, 577, S619–S625. [Google Scholar] [CrossRef]
- Misra, R.D.K.; Jia, Z.; O’Malley, R.; Jansto, S.J. Precipitation Behavior during Thin Slab Thermomechanical Processing and Isothermal Aging of Copper-Bearing Niobium-Microalloyed High Strength Structural Steels: The Effect on Mechanical Properties. Mater. Sci. Eng. A-Struct. 2011, 528, 8772–8780. [Google Scholar] [CrossRef]
- Han, G.; Xie, Z.J.; Xiong, L.; Shang, C.J.; Misra, R.D.K. Evolution of Nano-Size Precipitation and Mechanical Properties in a High Strength-Ductility Low Alloy Steel through Intercritical Treatment. Mater. Sci. Eng. A 2017, 705, 89–97. [Google Scholar] [CrossRef]
- Kang, J.; Heo, Y.; Kim, H.; Suh, D.; Son, D.; Lee, D.H.; Lee, T. Effect of Copper Addition on the Characteristics of High-Carbon and High-Chromium Steels. Mater. Sci. Eng. A 2014, 614, 36–44. [Google Scholar] [CrossRef]
- Karunaratne, M.S.A.; Yan, S.; Thomson, R.C.; Coghlan, L.; Higginson, R.L. Modelling carburisation in 9Cr-1Mo ferritic steel tube substrates in experimental CO2 atmospheres. Corros. Sci. 2019, 108248. [Google Scholar] [CrossRef]
- Kim, M.T.; Park, T.M.; Baik, K.H.; Won, S.C.; Pyuck-Pa, C.; Jeongho, H. Crucial microstructural feature to determine the impact toughness of intercritically annealed medium-Mn steel with triplex-phase microstructure. Acta Mater. 2019, 164, 122–134. [Google Scholar] [CrossRef]
- Andersson, J.O.; Helander, T.; Höglund, L.; Shi, P.; Sundman, B. Thermo-Calc & DICTRA, computational tools for materials science. Calphad 2002, 26, 273–312. [Google Scholar]
- Yin, H. Copper Precipitation Mechanism and Performance Control of Ferritic Antibacterial Stainless Steel. Ph.D. Thesis, University of Science and Technology Beijing, Beijing, China, 2016. [Google Scholar]
- Yin, H.; Zhai, A.; Zhao, Z.; Zhou, K.; Pei, W.; Yan, Y. Effects of annealing time on microstructure and properties of ultra purified ferritic stainless steel containing copper. Heat Treat. Met. 2015, 40, 109–113. [Google Scholar]
- Lin, G.; Shen, J.; Wang, R. Effect of Cu on the property of ferrite antibacterial stainless steel. J. Funct. Mater. 2011, 42, 549–551. [Google Scholar]
- Zou, D.; Zhang, W.; Zhang, S.; Bai, J.; Lin, Q.; Han, Y. Effect of antibacterial treatment on microstructure and properties of copper-bearing ferritic antibacterial stainless steel. Foundry Technol. 2005, 26, 1009–1011. [Google Scholar]
- Sun, S.; Zhao, A.; Ding, R.; Li, X. Effect of Heat Treatment on Microstructure and Mechanical Properties of Quenching and Partitioning Steel. Acta Metall. Sin. Engl. Lett. 2018, 31, 216–224. [Google Scholar] [CrossRef]
- Yong, Q. Secondary Phase in Steels; Press of Metallurgy Industry: Beijing, China, 2006. [Google Scholar]
- Pyykkö, P. Additive Covalent Radii for Single-, Double-, and Triple-Bonded Molecules and Tetrahedrally Bonded Crystals: A Summary. J. Phys. Chem. A 2014, 119, 2326–2337. [Google Scholar] [CrossRef] [PubMed]
- Tsuchiyama, T.; Yamamoto, S.; Hata, S.; Murayama, M.; Morooka, S.; Akama, D.; Takaki, S. Plastic Deformation and Dissolution of Ε-Cu Particles by Cold Rolling in an Over-Aged Particle Dispersion Strengthening Fe-2Mass%Cu Alloy. Acta Mater. 2016, 113, 48–55. [Google Scholar] [CrossRef]
- Sun, M.; Zhang, W.; Liu, Z.; Wang, G. Direct Observations on the Crystal Structure Evolution of Nano Cu-Precipitates in an Extremely Low Carbon Steel. Mater. Lett. 2017, 187, 49–52. [Google Scholar] [CrossRef]
- Wang, Z.; Li, H.; Shen, Q.; Liu, W.; Wang, Z. Nano-Precipitates Evolution and their Effects on Mechanical Properties of 17-4 Precipitation-Hardening Stainless Steel. Acta Mater. 2018, 156, 158–171. [Google Scholar] [CrossRef]

| C | Si | Mn | P | S | Cr | Ni | Cu | Fe |
|---|---|---|---|---|---|---|---|---|
| 0.003 | 0.19 | 0.23 | 0.009 | 0.001 | 17.04 | 0.34 | 2.07 | Balance |
| Sample | σ0.2/MPa | σm/MPa | A/% |
|---|---|---|---|
| No aging | 309 ± 3 | 403 ± 2 | 27 ± 1.0 |
| Aging | 472 ± 3 | 577 ± 4 | 22 ± 1.2 |
© 2020 by the authors. Licensee MDPI, Basel, Switzerland. This article is an open access article distributed under the terms and conditions of the Creative Commons Attribution (CC BY) license (http://creativecommons.org/licenses/by/4.0/).
Share and Cite
Sun, S.; Xue, Z.; An, L.; Chen, X.; Liu, Y. A Novel Design to Enhance the Mechanical Properties in Cu-Bearing Antibacterial Stainless Steel. Materials 2020, 13, 403. https://doi.org/10.3390/ma13020403
Sun S, Xue Z, An L, Chen X, Liu Y. A Novel Design to Enhance the Mechanical Properties in Cu-Bearing Antibacterial Stainless Steel. Materials. 2020; 13(2):403. https://doi.org/10.3390/ma13020403
Chicago/Turabian StyleSun, Shaoheng, Zhiyong Xue, Licong An, Xiaohua Chen, and Yifei Liu. 2020. "A Novel Design to Enhance the Mechanical Properties in Cu-Bearing Antibacterial Stainless Steel" Materials 13, no. 2: 403. https://doi.org/10.3390/ma13020403
APA StyleSun, S., Xue, Z., An, L., Chen, X., & Liu, Y. (2020). A Novel Design to Enhance the Mechanical Properties in Cu-Bearing Antibacterial Stainless Steel. Materials, 13(2), 403. https://doi.org/10.3390/ma13020403
